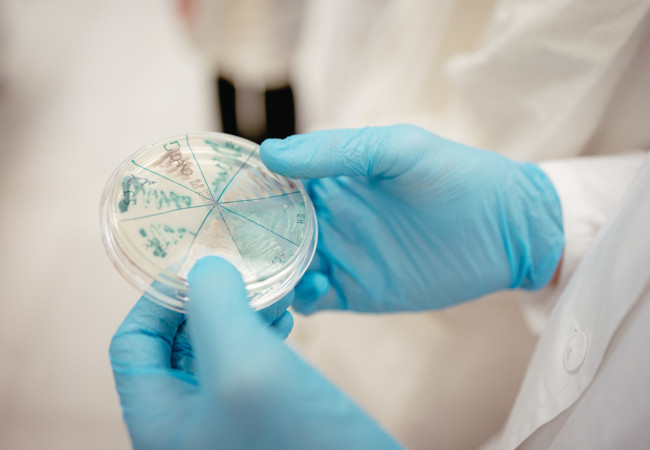
gymnazisti na truni, chemický krúžok, chémia, laboratórne metódy, fzsp truni

V utorok 5. 11. 2024 sa žiaci chemického krúžku zúčastnili fascinujúcej exkurzie na Fakulte zdravotníctva a sociálnej práce Trnavskej univerzity pri príležitosti 30. výročia založenia fakulty.
Vestibul a vstupný priestor foyer je ohromný. Navliekame laboratórny plášť a odkladáme veci do skriniek. Zarazím sa a nielen ja z batohu vytiahnem blok a pero. Ocitáme sa v laboratóriu označovanom ako L2 (biosafety level 2) a nasadzujeme si ochranné rukavice. Necháme sa zahaliť tichom, ktoré zaniká, ako sa stroje v laboratóriu prebúdzajú k činnosti. Pani laborantka Adámková všetko pre nás dôkladne prichystala.
Po rozdelení do skupín sa patogénom samozrejme vyhneme, no zamoria nás myšlienky, na ktoré sa nabaľujú stovky ďalších. Nakloním hlavu a uvažujem nad slovami pani docentky Kaiglovej. Pripravila si pre nás nielen veľmi odborný výklad o mRNA, ktorý dopĺňala, tak aby sme všetci porozumeli, ale aj úlohu na precvičenie.
Ochotne zodpovedala naše otázky o spomínaných vakcínach. Mikroskopom pátrame po známkach života. Je to zvláštny pocit, túžba miešajúca sa s hrôzou. Asistuje nám pani Mgr. Hockicková. Pozorujem niečo, čo ma doslova prirazí k zemi – geneticky upraveného pôdneho červíka hlístice Caenorhabditis elegans (háďatko obyčajné), ktorý vplyvom škodlivej látky bisfenol A zmenil svoju morfologickú štruktúru, teda tvar. Vieme, že bisfenol A sa nachádza sa v mikroplastoch, aký má dopad na celú planétu?

Neskôr nám pani docentka Kucharíková vysvetlila a ukázala, ako sa množia kvasinky. Nemali by ste, ale aj tak si k nim pričuchnete, môžete cítiť známe pekárenské droždie. Zaujímavé, kde všade sú kvasinky, nemám pravdu? Atmosféra v miestnosti náhle hustne. Prejde nami vlna úžasu, ako očkujeme vlastné kolónie kvasiniek.
Sklápam sklíčko a vraciam ho späť. V zapätí všetci dostaneme aj pochvalu za čistú prácu, pretože žiadna z platničiek nebola kontaminovaná. A výsledok? – jasne viditeľné krémovo sfarbené kolónie kvasiniek Candida albicans – posúďte sami na fotografiách.
Presúvame sa do vedľajšieho laboratória, kde s pani doktorkou Melnikov skúmame hodnoty pH rôznych látok, ako napríklad hydroxidu sodného alebo vaječného bielka. Niektoré zistenia nás mierne prekvapili. Vyskúšali sme si aj farebnú Biuretovu reakciu na dôkaz bielkoviny v roztoku, dôkazové reakcie sacharidov, či rôzne spôsoby kryštalizácie.
Za túto príležitosť, síce vo vyťaženom ale dobre zosúladenom harmonograme, sme veľmi vďační organizačnému výboru podujatia a Trnavskej univerzite, ktorá nám umožnila sa niečo dozvedieť a pozrieť sa na vedu zase o trošku inak.
Adam Ligač (II. DA)
Mgr. Róbert Knap